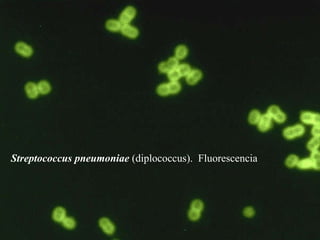
Streptococcus pneumoniae  (diplococcus).  Fluorescencia

1) O documento descreve as características e classificação de bactérias, incluindo sua estrutura, reprodução, diversidade metabólica e importância.
2) As bactérias têm estruturas como flagelos, pili e cápsulas, e se reproduzem de forma assexuada ou sexuada através de conjugação, transdução ou transformação.
3) As bactérias são metabolicamente diversas, podendo ser heterótrofas, autótrofas, fotossintéticas ou quimiossintéticas, e desempen